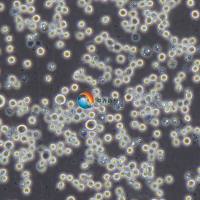
K-562/Adr 人白血病阿霉素耐药株

多重耐药与泛耐药有何根本区别
互联网
多重耐药菌(multiple resistant bacteria)是指有多重耐药性的病原菌。Multiresistance可以翻译成多药耐药性、多重耐药性,其定义为一种微生物对三类(比如氨基糖苷类、红霉素、B-内酰胺类)或三类以上抗生素同时耐药,而不是同一类三种。
泛耐药菌(pan resistant bacteria) 是指对除黏菌素外的所有临床上可获得抗生素均耐药的非发酵菌, 对几乎所有类抗菌素耐药。比如泛耐不动杆菌,对氨基糖苷、青霉素、头孢菌素、碳氢酶系 、四环素类、氟奎诺酮及磺胺类等耐药。
多重耐药性(multiple resistance, MDR) 系指同时对多种常用抗微生物药物发生的耐药性, 主要机制是外排膜泵基因突变, 其次是外膜渗透性的改变和产生超广谱酶。
最多见的是革兰阳性菌的MDR-TB和MDR-MRSA, 以及常在ICU中出现的鲍曼不动杆菌和铜绿假单胞菌,仅对青霉烯类敏感; 嗜麦芽窄食单胞菌几乎对复方新诺明以外的全部抗菌药耐药。MDR的出现决定了联合用药的必然; MDR菌株的高频率出现, 意味着抗微生物药物时代即将结束。
微生物耐药率不断增加的原因主要是:不合理使用和滥用,如美国用于人类抗感染与农牧业应用各占50%,其中用于院内抗感染仅占20%,而社区却占了80%,滥用率为20%~50%;在农牧业中治疗性应用仅占20%,而预防和促生长应用却占了80%,滥用率为40%~80%,每年有4万死亡病例是由耐药菌所致。
我国的滥用现象较美国更为严重,WHO对我国滥用抗菌药的评估是:中国97%的病毒性支气管感染患者使用了抗菌药;在初级医疗保健体系中30%~60%患者使用了抗菌药。
多重耐药菌的定义来源于美国CDC2006年发布的指南“Management of Multidrug-Resistant Organisms In Healthcare Settings, 2006 ”,其英文原为如下:
MDRO definition. For epidemiologic purposes, MDROs are defined as microorganisms, predominantly bacteria, that are resistant to one or more classes of antimicrobial agents (1).Although the names of certain MDROs describe resistance to only one agent (e.g., MRSA, VRE), these pathogens are frequently resistant to most available antimicrobial agents . 或者其附录中的解释:
Multidrug-resistant organisms (MDROs). In general, bacteria (excluding M. tuberculosis) that are resistant to one or more classes of antimicrobial agents and usually are resistant to all but one or two commercially available antimicrobial agents (e.g., MRSA, VRE, extended spectrum beta-lactamase [ESBL]-producing or intrinsically resistant gram-negative bacilli).